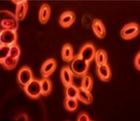
（圖）愛國細菌

愛國細菌
愛國細菌是俄羅斯科學院普通遺傳學研究所研製用於加工乳酸食品的新型酵母菌。由於用其加工出來的乳酸食品中含有的雙歧桿菌和乳酸菌,專門適合於俄羅斯人的體質,而被稱為愛國細菌。
特性
專家在研究中發現,這些菌群在不同種族中表現出的特性也不盡相同,從外國進口的乳酸飲料,對俄羅斯人並沒有表現出應有的有益特性。美國和西歐製造的生物酸奶等乳酸類飲料,對於俄羅斯人的體質並不十分適宜。如果俄羅斯人飲用符合自身基因特性的乳酸飲料,產生的效果將是進口產品的10倍。
功效
乳酸食品中含有的雙歧桿菌和乳酸菌對提高免疫力,維持腸道正常細菌群落,改善人體健康具有特殊功效。
針對性
俄羅斯科學家已經對15種雙歧桿菌和20種乳酸菌進行了驗證。這些細菌能夠抑制某些誘發急性和慢性疾病微生物的活性。由於俄羅斯60%的人口存在腸道健康問題,這項研究對改善俄
愛國細菌
愛國細菌羅斯人的腸道健康,提高俄羅斯民族健康水平具有重大意義。研究項目結束後,富含“愛國細菌”的新型乳製品將會很快出現在俄羅斯人的餐桌上。而該產品主要符合俄羅斯族的基因特性。
